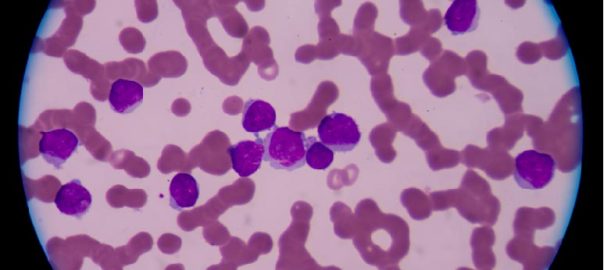

In the landscape of non-human primate (NHP) research, the spotlight frequently falls on Old World Monkeys (OWM) like the Macaque. However, for specific areas of biomedical inquiry—ranging from tropical medicine to complexRead More…
Chimpanzee Translational Medicine: What This Closest-Primate Model Still Teaches Us (and How Biospecimens Power Modern, Ethical Studies)
Why chimpanzees still matter in translational medicine—despite major research restrictions Chimpanzees (Pan troglodytes) sit at a unique intersection of biology and translational relevance. As our closest living relatives, they share deep similaritiesRead More…
Why Baboons Matter in Translational Research: A Practical Guide to Models, Biospecimens, and Readouts
When a program moves from “biology looks promising” to “we need evidence that will translate,” model choice becomes a strategy decision—not a checkbox. Among nonhuman primates (NHPs), baboons (genus Papio) occupy aRead More…
Marmosets in Translational Research: Why This Small Primate Is Making a Big Impact
If you work at the edge of discovery—where mechanistic biology must survive contact with real physiology—you’ve probably felt the gap between “works in rodents” and “works in primates.” The common marmoset (CallithrixRead More…
The African Green Monkey (Chlorocebus aethiops): A Crucial Non-Human Primate Model for Virology and Translational Medicine
The landscape of biomedical research is ever-evolving, demanding increasingly precise and reliable preclinical models to accelerate drug and vaccine development. While the Macaque species justly receives much attention, the African Green MonkeyRead More…
The Rhesus Macaque (Macaca mulatta): The Historical Cornerstone and Modern Frontline of Translational Research
The evolution of modern medicine owes a significant debt to the non-human primate (NHP) model. While numerous species contribute to preclinical testing, the Rhesus Macaque (Macaca mulatta) holds a unique, storied placeRead More…
The Indispensable Role of the Cynomolgus Monkey (Macaca fascicularis) in Modern Biomedical Research: An NHP Biologicals Perspective
The journey of a novel therapeutic, from benchside discovery to patient bedside, is fraught with complexity, risk, and rigorous testing. Navigating the crucial phase of preclinical development requires a model system thatRead More…
The Crucial Role of NHP In Vivo Pharmacokinetic Studies in Biologics Development Introduction: The Journey of a Biologic Drug
Developing a new biologic drug is a long and complex journey, a marathon of scientific inquiry and rigorous testing. From the initial discovery of a target protein to the final approval forRead More…
Advancing Biomedical Research with Non-Human Primate (NHP) Bone Marrow Cells
Introduction Non-Human Primates (NHPs) are considered the most physiologically relevant animal models for studying human diseases. Among the diverse types of NHP-derived biological materials, bone marrow cells hold exceptional value for preclinicalRead More…
Non-Human Primate Smooth Muscle Cells: A Cornerstone for Translational and Preclinical Research
Smooth muscle cells (SMCs) are integral components of various organ systems, playing essential roles in regulating vascular tone, airway constriction, and gastrointestinal motility. Among the available preclinical models, Non-Human Primate (NHP) smoothRead More…